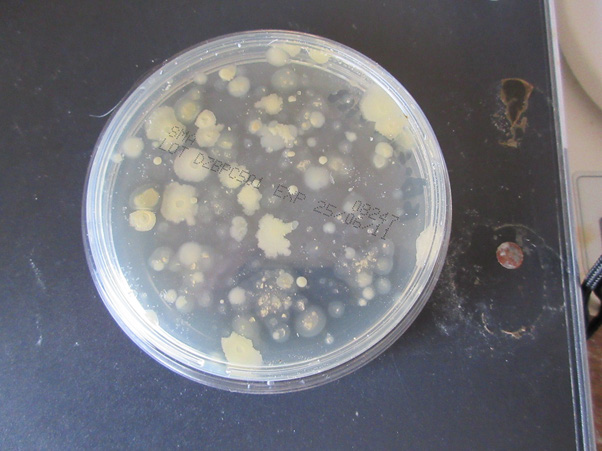
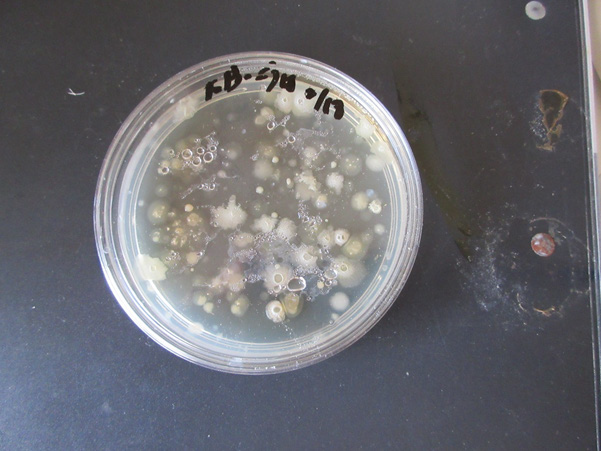
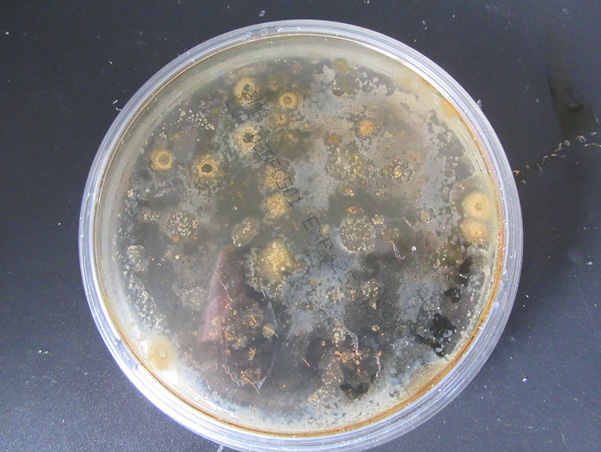
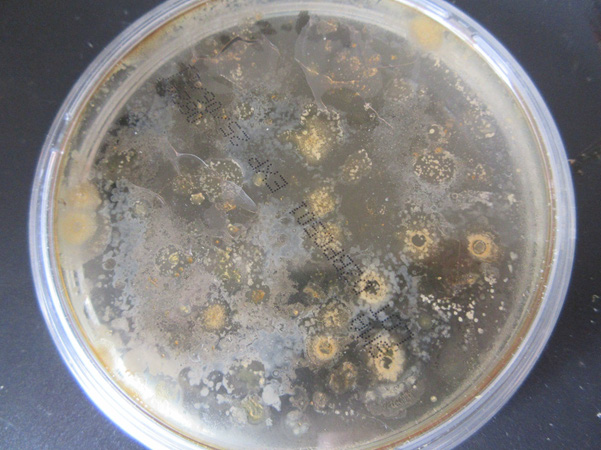
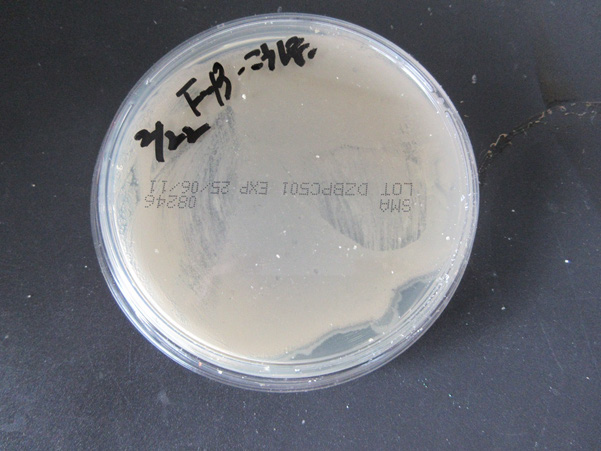

Research Article 
 Creative Commons, CC-BY
Creative Commons, CC-BY
Separation of Antibiotic-Producing Cells from Agar Culture of Egg Powder-Enclosed DNA (hepatoblastoma cell line; HepG2) Crown Cells and Yeast
*Corresponding author: Shoshi Inooka, Japan Association of Science Specialists, 3-8-2 Nakada, Taihaku-ku, Sendai 981-1104, Japan.
Received: March 08, 2025; Published: March 12, 2025
DOI: 10.34297/AJBSR.2025.26.003417
Abstract
Synthesized DNA crown cells can be synthesized using sphingosine (Sph)-DNA-adenosine-monolaurin compounds, and DNA crown cells were prepared using egg white. In previous experiments, it was demonstrated that antibiotic was produced in co-cultures of yeast and DNA (Streptomyces) crown cells, and that antibiotic-producing cells were separated from beer, from objects that were formed in the cultures of synthetic DNA (Streptomyces) crown cells and from the egg-white powder which enclosed DNA (Streptomyces) crown cells and yeast. Antibiotic-producing cells could be separated with the stimulation of egg white or monolaurin.
Here, it was examined whether antibiotic-producing cells could be separated using other DNA (HepG2) crown cells. The results showed that antibiotic-producing cells could be separated from agar cultures produced using powdered DNA (HepG2) crown cells with yeast enclosed within egg white. These cells were named antibiotic producing Crown-HepG2-Yeast cells.
Keywords: DNA (HepG2) crown cells, Sphingosine-DNA, antibiotic producing Crown-HepG2-Yeast-cells, Monolaurin
Introduction
Self-replicating artificial cells were first reported in 2012 [1] and the principal methods to prepare these artificial cells were reported in 2016 [2]. These cells were referred to as DNA crown cells in 2016 by the present author [3]. Their exterior consists of DNA. Synthetic DNA crown cells were synthesized using the following four common commercial compounds: Sphingosine (Sph), DNA, adenosine, and monolaurin. The cells developed into fully self-replicating DNA crown cells when incubated in egg white.
In previous studies, various types of objects were observed when monolaurin-treated synthetic DNA (E. coli/Human placenta/ Ascidian, Streptomyces) crown cells were cultured with or without egg white on agar plates [4-7].
On the other hand, it was demonstrated that antibiotic-producing cells could be isolated from beer. These cells were produced in co-cultures of DNA crown cells with yeast [8] and from the objects that were created on agar plate cultures of synthetic DNA (Streptomyces) crown cells and monolaurin or egg white [9].
In addition, antibiotic-producing cells were separated from egg-white powder which enclosed DNA (Streptomyces) crown cells and yeast [10]. These examples of antibiotic production or the production of antibiotic-producing cells were demonstrated using DNA (Streptomyces) crown cells, which have a gene for antibiotic synthesis.
In the present experiments, it was examined whether antibiotic production was observed in DNA crown cells other than DNA (Streptomyces) crown cells. The findings showed that antibiotic-producing cells could be separated in agar cultures of egg-white powder that had been used to enclose DNA(HepG2) crown cells with yeast. These new cells are named antibiotic crown HepG2-yeast-cells-ap.
Materials and Methods
Materials
DNA (HepG2) crown cells were prepared previously [11-13] and used in this study. However, the methods are repeated here for clarity and convenience. The materials used were the same as those employed in previous studies [11-13]: Sph (Tokyo Kasei, Japan), DNA (From HepG2 cells), adenosine (Sigma-Aldrich, USA; Wako, Japan), monolaurin (Tokyo Kasei,), and adenosine-monolaurin (A-M), a compound synthesized from a mixture of adenosine and monolaurin [12,13]. Monolaurin solutions were prepared to a final concentration of 0.1 M in distilled water. Agar plates were prepared using standard agar medium (SMA) (AS ONE, Japan), and dry ale yeast (SafAle S-04) was obtained from Formentis (Marcqen- Baroeul, France).
Other reagents included: Dulbecco’s minimal essential medium (D-MEM) (Sigma), bovine serum (Sigma), potato dextrose agar (PDA) (Kyodo Nyugiou, Tokyo, Japan), and Bacillus subtilis (Daikokuya, Nagoya, Japan).
Methods
Preparation of synthetic DNA (HepG2) crown cells [11-13]. Briefly, Sph (10 mM) and DNA (0.3 μg/μL) were combined, and the mixture was heated and cooled twice. Then, A-M solution was added and the mixture was incubated for 15 minutes at 37℃.
After monolaurin solution was added, the mixture was incubated for 5 minutes at 37℃.
The suspension (0.2~0.3 ml) of these synthetic DNA(HepG2) crown cells was then added to egg white and incubated for 7 days at 37°C. Then, the egg white was recovered and used as DNA for (HepG2) crown cells.
Powder was prepared as described previously [10].
1) First, 3 ml of yeast suspension (10 mg/ml) was mixed with 3 ml of egg white. 2) The mixture was then incubated for 5 hours at 37℃. 3) Then, about 25 ml of fresh egg white was added to the mixture. 4) The fluids were plated onto two Petri dishes and dried for 1-2 days at 37℃. 5) The dried material was then collected and used to prepare a powder using a mortar. 6) The powder (Figure 1), named Antibiotic crown HepG2-Yeast-P, was stored at room temperature and used as necessary.
To prepare the samples for antibiotic analysis, a small amount (40~50mg) of powder was added to each agar plate and incubated for 2 days at 37℃.
Then, approximately 1.5 ml of 0.1 M monolaurin solution was poured onto each plate, which was incubated for 2 days at 37℃. About 5.0 ml of distilled water was then added to each plate and dispersed on the plate surface. Then, the objects on the plate were recovered. A 200 μL of the recovered objects was incubated in 5 ml of D-MEM containing 10% bovine serum for 1 and 3 days at 37℃. The culture liquid was used as the sample A for testing.
In addition, 200 μL of collected sample was poured into an agar plate and incubated for 1 day at 37℃. Then, picking cultured objects were incubated in 5 ml of D-MEM containing 10% bovine serum for 2-5 days. This culture fluid (sample B) was used for the antibiotic assays. The rest of the sample was stored after treatment, as described below.
Preparation Antibiotic ASSAYS
The antibody assay was carried out using the agar well method, as described previously [8]. Briefly, the test bacteria (Bacillus subtilis) were mixed with agar medium and poured onto Petri plates. A well was prepared in each plate and the test fluid (about 400 μL) was added to the well. The plates were then incubated for 2 days at 37℃. After incubation, the zone of inhibition was observed.
The remainder of the sample was diluted in a total of 5.0 ml of distilled water and added to about 10 ml of egg white solution. After mixing, the samples were dried in a dish within an incubator at 37℃ for 1-2 days.
The dried materials, named antibiotic producing Crown HepG2- yeast cells, were prepared in a powder as described above.
Results
Figure 2 shows a photograph of an agar plate immediately culturing the powder (i.e., Antibiotic Crown HepG2-yeast-p) on agar. Powder particles of various sizes were observed in the Petri dish, which had a diameter of 8.0 cm.

Figure 2: Photograph of an agar plate after immediately preparing an agar culture of the powder. Powder particles of various sizes were observed in the Petri dish, which had a diameter of 8.0 cm.
Figure 3 shows a photograph of an agar plate at 1 day after powder addition and culture on agar. Round objects of various sizes, visible with the naked eye, were observed on the Petri dish. Figure 4 shows a photograph of an agar plate at 2 days after powder addition and culture on agar. Round objects of various sizes were observed, including circular shaped objects.
Figure 3: Photograph of an agar plate at 1 day after powder addition and culture on agar. Round objects of various sizes, visible with the naked eye, were observed on the Petri dish.
Figure 4: Photograph of an agar plate at 2 days after powder addition and culture on agar. Round objects of various sizes were observed, including circular-shaped objects.
Figure 5 shows a photograph of an agar plate at 1 day after monolaurin addition. Round brown objects of various sizes were observed.
Figure 5: Photograph of agar plate at 1 day after monolaurin addition. Round brown objects of various sizes were observed.
Figure 6 shows a photograph of an agar plate at 2 days after monolaurin addition.
Figure 6: Photograph of an agar plate at 2 days after monolaurin addition. Brown objects of various sizes and shapes were observed. Also, dot-like objects were observed within round objects.
Brown objects of various sizes and shapes were observed. Also, dot-like objects were observed within round objects.
Figure 7 shows a photograph of agar plate at 1 day of sample culture. Objects similar to microorganisms were observed over the entire plate.
Figure 7: Photograph of agar plate at 1 day of sample culture. Objects similar to microorganisms were observed over the entire plate.
Figure 8 shows a photograph of an agar plate used to assay antibiotics in samples A prepared from powder (i.e. antibiotic crown HepG2- yeast-p).

Figure 8: Photograph of an agar plate used to assay antibiotics in samples A. A clear inhibition zone was observed around the edge of the well.
A clear inhibition zone was observed around the edge of the well.
Figure 9 shows a photograph of agar plate used to assay antibiotics in samples B. prepared from objects in Figure 7 (i. c antibiotic- producing crown HepG2)-yeast cells).

Figure 9: Photograph of an agar plate used to assay antibiotics in samples B, focusing on objects observed in Fig. 7. A clear inhibition zone was observed.
A clear inhibition zone was observed.
The clear inhibition zone observed in this study was smaller than observed in previous studies [8-10]. suggesting that the activity of the antibiotic to Bacillus was lower than that observed in previous studies.In a previous study, an antibiotic was produced in co-cultures of yeast and DNA (Streptomyces) crown cells during beer production. Antibiotic-producing cells were separated from the beer following stimulation with egg white or monolaurin [8]. Moreover, in experiments involving agar plate cultures of synthetic DNA crown cells with egg white or monolaurin, various objects were observed [4-7].
Also, antibiotic-producing cells were isolated from the objects that formed in agar cultures of synthetic DNA (Streptomyces) crown cells containing egg white and monolaurin [9]. DNA (Streptomyces) crown cells were mixed with yeast and processed into powder with egg white, from which antibiotic-producing cells were subsequently separated [10].
In previous experiments [8-10], DNA (Streptomyces) crown cells containing genes for antibiotic production were used, and antibiotic-producing cells were successfully separated in combination with yeast. In this study, experiments used DNA (HepG2) crown cells, and antibiotic-producing cells were also separated. The results showed that the production of such cells is not specific to DNA (Streptomyces) crown cells and suggest that antibiotic-producing cells can be produced using various kinds of DNA crown cells using the same methods, i.e., stimulation with egg white or monolaurin, using powdered materials [10].
Also, as described previously [8-10], no experiments have been conducted on the origin of these cells or the characteristics of the antibiotics produced. It is important to determine whether the emergence of such cells in response to stimulation using egg white or monolaurin is associated with DNA crown cells, or whether these originate from DNA crown cells. If the latter is the case, then the present cells may possess additional characteristics derived from HepG2 (tumor) cells, in addition to their antibiotic-producing ability acquired from Bacillus subtilis. This could have implications for various applications in cancer research, including the development of anticancer agents and the elucidation of cancer formation mechanisms.
All experiments were carried out using yeast in combination with DNA crown cells (hereafter referred to as the “yeast partner” for DNA crown cells). It remains unclear whether antibiotic-producing cells can be separated when using a partner other than yeast. Therefore, it is necessary to clarify the role of the partner in the production of antibiotics or antibiotic-producing cells.
Future studies will investigate whether other antibiotic-producing cells can be separated when DNA crown cells are combined with partners other than yeast, including living and non-living substances.The antibiotic-producing cells identified in this study were designated as antibiotic-producing Crown HepG2- yeast cells. Additionally, the powder from which these cells originate is named Antibio Crown HepG2-yeast-P, where P denotes the powdered egg white.
The antibiotic identified in the present experiments represents the fourth in this series of findings. Therefore, it is designated here as Crown Antibiotic-4.
Acknowledgements
None.
Conflicts of Interest
None.
References
- Inooka S (2012) Preparation and cultivation of artificial cells. App Cell Biol 25: 13-18.
- Inooka S (2016) Preparation of Artificial Cells Using Eggs with Sphingosine-DNA. J Chem Eng Process Technol l7: 277.
- Inooka S (2016) Aggregation of sphingosine-DNA and cell construction using components from egg white. Integrative Molecular Medicine 3(6): 1-5.
- Inooka S (2024) Synthesis and Microscopic Appearance of Thalus-like Objects tin Synthetic DNA (E. coli) Crown Cells Created Using Monolaurin and Egg white. Open Access Journal of Reproductive System and Sexual Disorder 3(2).
- Inooka S (2024) Double Cell-Like Objects Created from synthetic DNA (Human Placenta) Crown Cells using Monolaurin. American Journal of Medical and Clinical Science 9(2): 106-126.
- Inooka S (2024) Morning glory-and Dandelion-like Objects Created in Agar Cultures of Synthetic DNA (Ascidian) Crown Cells with Monolaurin and Egg white. Annals of Reviews & Research 10(8).
- Inooka S (2024) Cell ring-like objects created in agar cultures of synthtic DNA (Streptomyces) cells with monolaurin. Clinical Cardiology and Cardio vascular Interrventions 7(7).
- Inooka S (2025) Separation of Antibiotic-Producing Cells from Beer Produced in Co-cultures of DNA (Streptomyces) Crown Cells with Yeast Annals of Reviews and Research 12(3).
- Inooka S Separation of antibiotic producing cells from the agar cultures of synthetic DNA (Streptomyces) crown cedlls with monolaaurin and egg white a In Submission.
- Inooka S Separation of antibiotic producing cells from culture fluids of egg white powder enclosed DNA(Streptomyces) crown cells and yeast. In Submission.
- Inooka S (2023) Preparation of a DNA (Hepatoblastoma-Deraived Cell Line: HepG2) Crown Cell line. Journal of Tumor Medicine & Prevence 4(2).
- Inooka S (2017) Biochemical and Systematic Preparation of Artificial Cells. The Global Journal of Research in Engineering 17(11).
- Inooka S (2017) Systematic Preparation of Artificial Cells (DNA Crown Cells) J. Chem Eng Procces Tecnolo 8(327).




 We use cookies to ensure you get the best experience on our website.
We use cookies to ensure you get the best experience on our website.